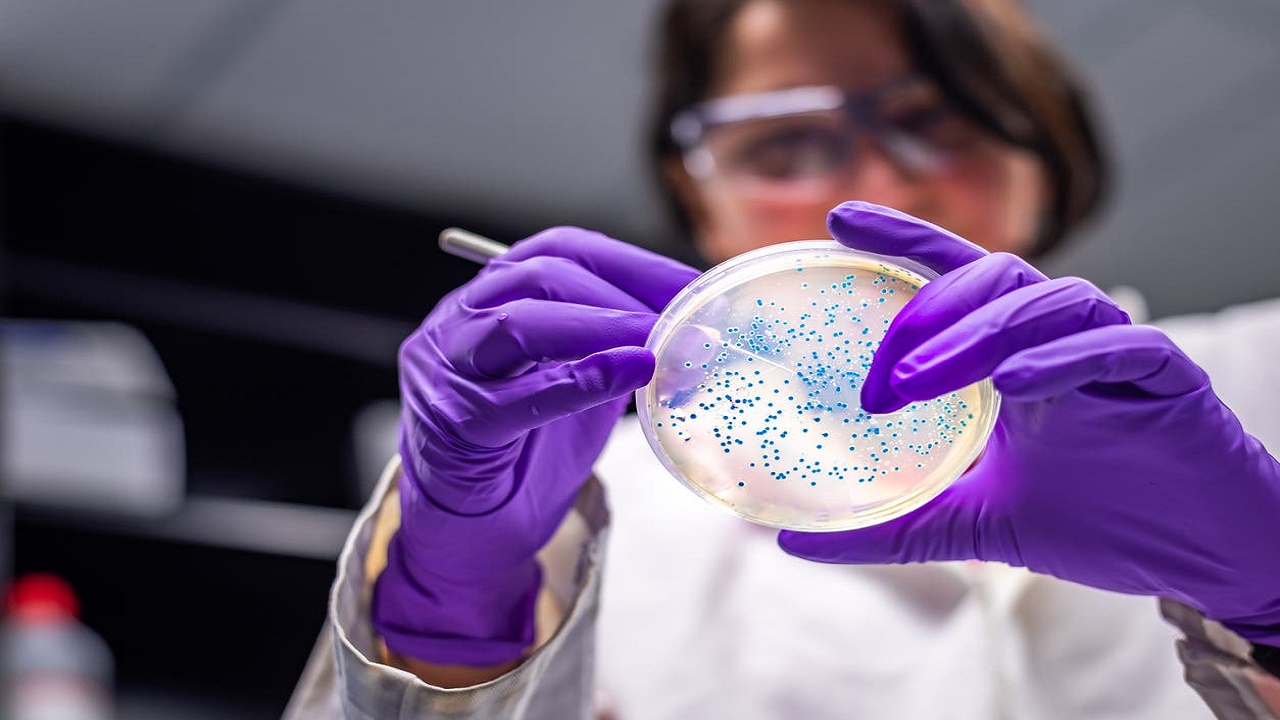

اكتشاف يحدّد 6 أنواع لـ "كورونا" بأعراض متنوعة
حلّل علماء بريطانيون بيانات تطبيق واسع الاستخدام، يسجل أعراض المرض، وجدوا نتيجة هائلة مفادها أن هناك ستة أنواع مختلفة للوباء، ولكل منها مجموعة من الأعراض.
واكتشف فريق بكلية "كينجز كوليدج لندن" أن الأنواع الستة مرتبطة أيضاً بمستويات شدة العدوى، وباحتمال احتياج المريض لمساعدة على التنفس، مثل تزويده بالأكسجين أو جهاز للتنفس الاصطناعي.
ومن الممكن أن يساعد هذا الكشف الأطباء خلال أي موجات مقبلة للوباء في تحديد أي المرضى يواجه مخاطر كبيرة ويحتاج الى رعاية داخل مستشفى.
بدورها، أفادت الدكتورة كلير ستيف، التي شاركت في قيادة الفريق، بأنه إذا أمكن تحديد نوع العدوى "فلديك الوقت لمساعدة المريض والتدخل المبكر، مثل مراقبة الأكسجين ومستويات السكر في الدم، وضمان وفرة السوائل بشكل ملائم".
يذكر أن الأطباء كانوا بدأوا، أخيراً، برصد أعراض مختلفة جديدة لفيروس كورونا لدى المصابين الشباب الذين تزايدت أعدادهم في الآونة الأخيرة.
ويشعر المصابون بـ«كورونا» تحت سن 35 بأعراض مثل ألم البطن، والصداع، على خلاف الأعراض التي تنتاب بقية المرضى الأكبر سناً، مثل الحمى والسعال.
إلى ذلك، أودى الفيروس حتى الآن بحياة 590 ألفاً و132 شخصاً على الأقل في جميع أنحاء العالم منذ ظهر في الصين في ديسمبر من العام الماضي.



